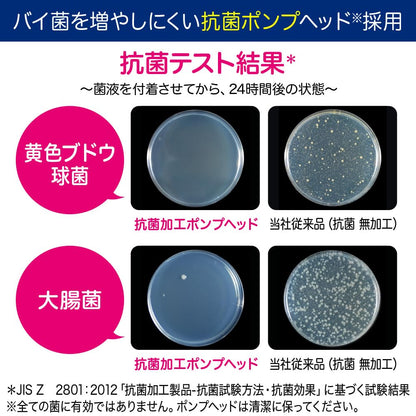
Biore U Foam Stamp 240ml Nikukyu Hand Soap Body Quasi-Drug

Biore U Foam Stamp 240ml Nikukyu Hand Soap Body Quasi-Drug
Combina bien con
Los aranceles, impuestos y cargos de importación son responsabilidad del cliente. Detalles aquí.
Envío directamente desde Japón
Ventana de devolución de 60 días

Biore U Foam Stamp 240ml Nikukyu Hand Soap Body Quasi-Drug
Información del producto
Acerca de Japón con amor
Japan With Love se estableció en diciembre de 2020 con grandes experiencias y comprensión de los productos japoneses. Ofrecemos una amplia gama de cosméticos, suplementos, alimentos, utensilios de cocina y más. Se fabrican y envían directamente desde Japón con una garantía 100% auténtica.
Si tiene alguna pregunta, siempre puede ponerse en contacto con nosotros. Nos pondremos en contacto con usted lo antes posible, dentro de las 24 horas en días laborables.
-
Información de envío
Utilice este texto para responder a las preguntas con el mayor detalle posible para sus clientes.
-
Atención al cliente
Utilice este texto para responder a las preguntas con el mayor detalle posible para sus clientes.
-
Preguntas frecuentes
Utilice este texto para responder a las preguntas con el mayor detalle posible para sus clientes.
-
Contáctenos
Utilice este texto para responder a las preguntas con el mayor detalle posible para sus clientes.
If you have any questions, you are always welcome to contact us. We'll get back to you as soon as possible, within 24 hours on weekdays.
Preguntas frecuentes
Por favor, lee nuestra página de Preguntas frecuentes para obtener más información.
¿Son auténticos sus productos?
Sí, todos nuestros artículos son 100% auténticos y se envían directamente desde Japón. Trabajamos solo con socios oficiales y proveedores de confianza.
¿Ofrecen envío gratuito?
Ocasionalmente ofrecemos descuentos de envío. Consulta las tarifas actuales al finalizar la compra y suscríbete aquí para recibir actualizaciones sobre promociones, consejos y más. Para obtener todos los detalles relacionados con el envío, visita nuestra página de Política de envío.
¿Qué es la Protección de Envío y por qué debería elegirla?
Protección de Envío es un complemento opcional que cubre la pérdida, el robo o los daños durante el tránsito. Para su tranquilidad, le recomendamos encarecidamente que la seleccione al finalizar la compra, especialmente para los pedidos internacionales.
¿Tengo que pagar aranceles o impuestos de importación?
Sí. Los aranceles de importación son responsabilidad del cliente y varían según el país. Consulte sus regulaciones locales antes de realizar el pedido.
¿Puedo devolver o cambiar un artículo?
Sí, ofrecemos un plazo de devolución de 60 días para los artículos que lleguen dañados, defectuosos o incorrectos. Lea más sobre nuestra Política de devoluciones.
¿Necesito una cuenta para realizar un pedido?
No, puedes pagar como invitado. Pero crear una cuenta permite un pago más rápido, seguimiento de pedidos y gestionar tus preferencias.


